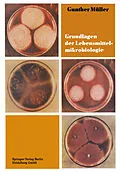

Titel
Grundlagen der Lebensmittelmikrobiologie
Untertitel
Eine Einführung
Autor
EAN
9783662414606
ISBN
978-3-662-41460-6
Format
E-Book (pdf)
Hersteller
Herausgeber
Genre
Veröffentlichung
11.12.2013
Digitaler Kopierschutz
Wasserzeichen
Anzahl Seiten
267
Jahr
2015
Untertitel
Deutsch
Auflage
3. Auflage 1977
Lesemotiv
Unerwartete Verzögerung
Ups, ein Fehler ist aufgetreten. Bitte versuchen Sie es später noch einmal.